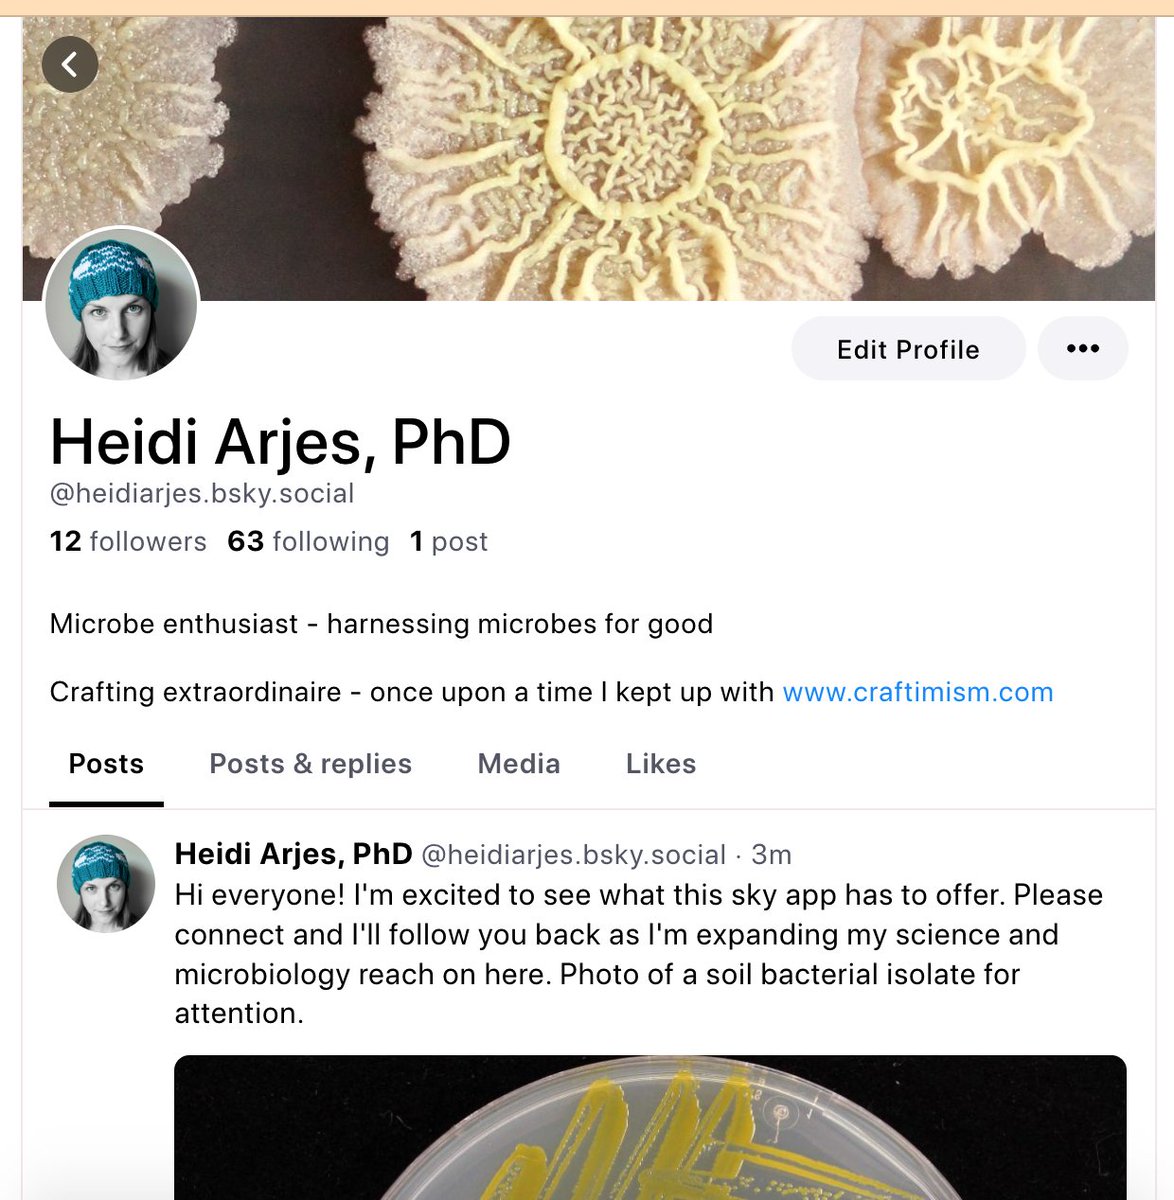
I'm liking it so far! Please find me: 

bsky.app/profile/heidia…

Dr. Heidi Arjes
@heidiarjes
Microbiologist, fiber artist, crafting enthusiast. I merge science and knitting at craftimism.com she/her
ID: 2658493243
http://www.craftimism.com 19-07-2014 02:47:24
1,1K Tweet
803 Followers
629 Following

Congratulations, Katherine Xue

Stoked to share the peer-reviewed version of my paper with Peter Lind & Sutirth Dey: rdcu.be/deBG9 A bit delayed in sharing this as I recently became a dad! We'd love to hear your thoughts! @Lmchev Will Ratcliff Akos T. Kovacs @CGhalambor Katrin Hammerschmidt 1/15


Redesign of an Escherichia coli Nissle treatment for phenylketonuria using insulated genomic landing pads and genetic circuits to reduce burden from the Christopher Voigt lab: doi.org/10.1016/j.cels…


My new favourite climate graphic From Jane Morton Jane Morton's excellent free booklet 'Don't Mention the Emergency?'










Please share: Are you a recent graduate looking for more lab experience? Are you organized and love spending other people’s money? I am hiring a tech to support the lab-to start ASAP! The position is for a year (can be extended if funding allows) amherst.wd5.myworkdayjobs.com/en-US/Amherst_…



Congrats, Zachary Hallberg et al! Vitamin B12 variants structure soil microbial communities despite soil’s vast reservoir of B12 biorxiv.org/content/10.110…